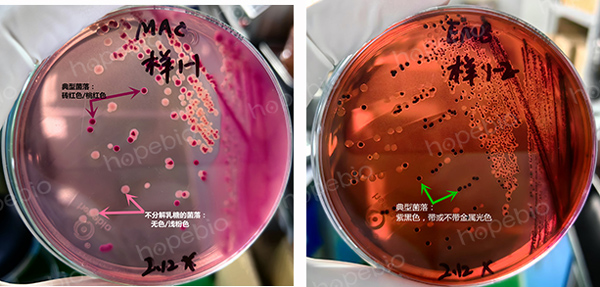

海博微信公众号
海博微信公众号
 海博天猫旗舰店
海博天猫旗舰店


 海博微信公众号
海博微信公众号
 海博天猫旗舰店
海博天猫旗舰店




一、引言
致泻大肠埃希氏菌(Enteropathogenic Escherichia coli,简称EPEC)是一种重要的肠道病原菌,主要引起婴幼儿腹泻,尤其在发展中国家,EPEC感染是导致婴幼儿腹泻和死亡的主要原因之一。EPEC属于大肠埃希氏菌(Escherichia coli)的一种致病性亚型,其致病机制和流行病学特征使其成为公共卫生领域的重要研究对象。其在选择性平板上的生长特征如图1。
图1 致泻大肠埃希氏菌在不同的选择性平板上的典型生长特征
(左:MAC平板,砖红色或桃红色菌落; 右:EMB平板,紫黑色,带或不带金属光泽)
二、致泻大肠埃希氏菌的分类与特征
大肠埃希氏菌(E.coli)是一种常见的革兰氏阴性杆菌,广泛存在于人和动物的肠道中。大多数E.coli菌株是无害的,甚至对肠道健康有益,但某些菌株具有致病性,能够引起肠道或肠外感染。根据其致病机制和临床表现,致病性大肠埃希氏菌可分为多种类型,包括肠致病性大肠埃希氏菌(EPEC)、肠产毒性大肠埃希氏菌(ETEC)、肠侵袭性大肠埃希氏菌(EIEC)、肠出血性大肠埃希氏菌(EHEC)等。
EPEC是最早被识别出的致病性E.coli之一,主要引起婴幼儿腹泻。EPEC的特征之一是其能够形成“附着和抹平”病变(Attaching and Effacing,A/E病变),这是其致病机制的核心。
有关致泻大肠埃希氏菌的一些知识资料,点击查看。
三、致病机制
EPEC的致病机制主要依赖于其与宿主肠上皮细胞的相互作用。EPEC通过一系列毒力因子介导其致病过程,主要包括以下几个步骤:
1、粘附:EPEC通过菌毛等粘附因子与肠上皮细胞表面结合。EPEC的粘附因子包括束形成菌毛(Bundle-forming pili,BFP),这些菌毛帮助细菌在肠上皮细胞表面形成微菌落。
2、A/E病变形成:EPEC通过III型分泌系统(Type III Secretion System,T3SS)向宿主细胞注入效应蛋白,如Tir(Translocated intimin receptor)蛋白。Tir蛋白插入宿主细胞膜后,与EPEC表面的intimin蛋白结合,导致宿主细胞骨架重排,形成A/E病变。A/E病变的特征是微绒毛的破坏和细胞表面的抹平。
3、炎症反应:EPEC感染还会引发宿主细胞的炎症反应,导致肠道上皮细胞损伤和腹泻。EPEC通过效应蛋白调节宿主细胞的信号通路,促进炎症因子释放。
四、临床表现与流行病学
EPEC感染主要引起婴幼儿腹泻,尤其是在6个月至2岁的儿童中较为常见。感染的症状包括水样腹泻、呕吐、发热和脱水,严重时可导致营养不良和死亡。EPEC感染在发展中国家尤为普遍,主要由于卫生条件差、饮用水污染和食品卫生问题。
EPEC的传播途径主要是粪-口途径,通过摄入被污染的食物或水传播。在卫生条件较差的地区,EPEC感染容易在家庭或社区中暴发流行。
五、诊断与治疗
EPEC感染的诊断主要依赖于实验室检测。常用的方法包括粪便培养、PCR检测和免疫学方法。由于EPEC的A/E病变是其重要的致病特征,检测A/E病变相关基因(如eae基因)是诊断EPEC感染的重要手段。
EPEC感染的治疗主要包括补液和支持疗法,以防止脱水和电解质紊乱。抗生素治疗在EPEC感染中的作用有限,且由于抗生素耐药性的增加,抗生素的使用应谨慎。预防EPEC感染的关键在于改善卫生条件、确保饮用水安全和加强食品卫生管理。
六、预防与控制
预防EPEC感染的关键在于切断其传播途径。以下措施可以有效降低EPEC感染的风险:
(1)改善卫生条件:确保饮用水的安全,避免饮用未经处理的水源。
(2)加强食品卫生:避免食用未煮熟的食物,尤其是肉类和奶制品。
(3)个人卫生:勤洗手,尤其是在处理食物和如厕后。
(4)健康教育:提高公众对EPEC感染的认识,尤其是在高风险地区。
七、结论
致泻大肠埃希氏菌(EPEC)是一种需要严格管控的肠道病原菌,主要引起婴幼儿腹泻,尤其在发展中国家具有较高的发病率和死亡率。EPEC的致病机制复杂,涉及粘附、A/E病变形成和炎症反应等多个步骤。通过改善卫生条件、加强食品卫生管理和提高公众健康意识,可以有效预防和控制EPEC感染。未来,随着对EPEC致病机制的深入研究,有望开发出更有效的预防和治疗策略,减少EPEC感染对全球公共卫生的威胁。
注:本文属海博生物原创,未经允许不得转载。
上一篇:致泻大肠埃希氏菌生化检验
下一篇:李斯特氏菌的协同溶血试验
| 相关文章: | ||



